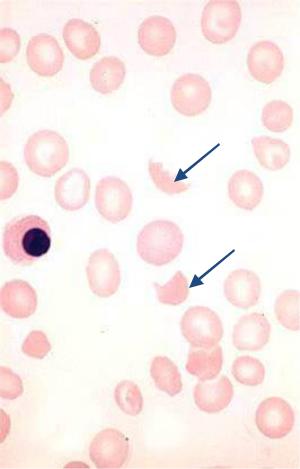
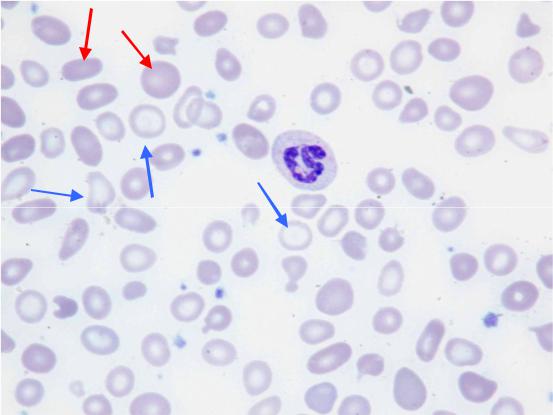

Материал: клинический+анализ+крови+2

Изменения размера и формы эритроцитов
Семейный акантоцитоз при а- -липопротеидемии
Акантоциты – шиповатыеэритроциты. Они имеют несколько выпячиваний цитоплазмы разных размеров

Изменения размера и формы эритроцитов
Стрелкой показанполихроматофил
•Эхиноциты имеют множество мелких выпячиваний мембраны.
•Единичные эхиноциты встречаются у здоровых людей
•В большом количестве они могут быть при почечной и печёночной недостаточности
•Часто встречается ложный эхиноцитоз, обусловленный длительным нахождением эритроцитов в жидкости с ЭДТА пред приготовление мазка или нарушением фиксации мазка крови
Изменения размера и формы эритроцитов
Фрагменты эритроцитов – фрагментоциты, (шистоциты, шизоциты) в мазках крови здорового человека встречаются очень редко (0,05-0,08%; максимально 0,27%). Если они легко обнаруживаются при просмотре мазка крови, надо думать о гиперагрегации тромбоцитов, что встречается при остром синдроме ДВС и тромботической тромбоцитопенической пурпуре (болезнь Мошковица). Эритроциты разрезаются на фрагменты, проходя через рыхлые тромбоцитарные агрегаты.

Схема образования фрагментоцитов
Фрагмент агрегата тромбоцитов.
Псевдоподиеподобные отростки тромбоцитов соединены молекулами фибриногена через конформированные рецепторы IIb/IIIa.
Образование фрагментов эритроцитов.
Направление кровотока
Анизохромия, анизоцитоз и пойкилоцитоз эритроцитов
Видны крупные (круглые и овальные) гиперхромные эритроциты (красные стрелки), гипохромные эритроциты разных размеров и формы (синие стрелки); нейтрофил, отдельные тромбоциты.